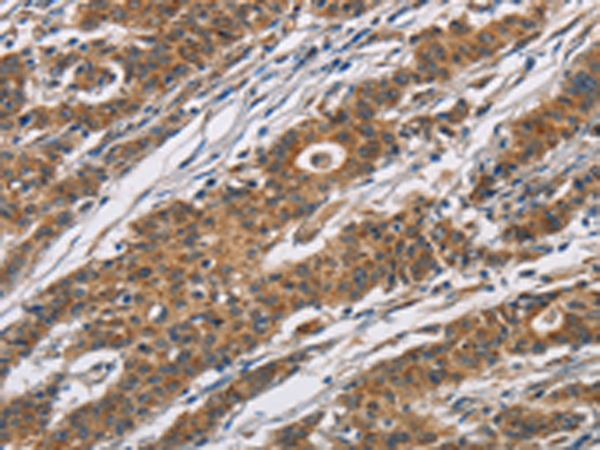

|
Background: |
This gene encodes a member of the cytochrome P450 superfamily of enzymes. The cytochrome P450 proteins are monooxygenases which catalyze many reactions involved in drug metabolism and synthesis of cholesterol, steroids and other lipids. This protein localizes to the endoplasmic reticulum and hydroxylates steroids at the 21 position. Its activity is required for the synthesis of steroid hormones including cortisol and aldosterone. Mutations in this gene cause congenital adrenal hyperplasia. A related pseudogene is located near this gene; gene conversion events involving the functional gene and the pseudogene are thought to account for many cases of steroid 21-hydroxylase deficiency. Two transcript variants encoding different isoforms have been found for this gene. |
|
Applications: |
ELISA, IHC |
|
Name of antibody: |
CYP21A2 |
|
Immunogen: |
Fusion protein of human CYP21A2 |
|
Full name: |
cytochrome P450, family 21, subfamily A, polypeptide 2 |
|
Synonyms: |
CAH1; CPS1; CA21H; CYP21; CYP21B; P450c21B |
|
SwissProt: |
P08686 |
|
IHC positive control: |
Human gastric cancer and human thyroid cancer |
|
IHC Recommend dilution: |
100-300 |
購物車
購物車 幫助
幫助
 021-54845833/15800441009
021-54845833/15800441009
